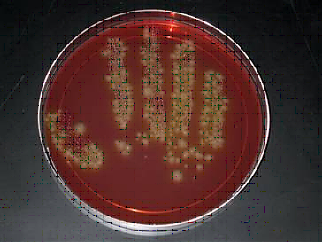

“Zero tolerance to infection” should be every healthcare worker’s (HCW) motto.
This module on hand hygiene in the healthcare setting has been made with the objective of understanding the importance of hand hygiene in healthcare, improving hand hygiene awareness and practices among HCWs and, thereby, achieving the goal of reduced infection rates.
- According to the World Health Organization (WHO), it is estimated that globally, at any given time, approximately 1.4 million patients have a healthcare-associated infection (HCAI).
- When one thinks of healthcare, what first comes to mind are the operations, investigations and medications. But, we forget about the hands — they remain overlooked and unspoken of.
- hands are often referred to as providing the healing touch; in a healthcare setting, this is probably what hands should really do. But, in certain cases, they can be the cause for transferring harmful germs to the susceptible patient.
- If seeing is believing, here is proof. The image below is an actual impression of the unwashed hand of a nurse. Sometimes, hands can carry 104 infectious organisms/sq cm.
- Hands are considered as the most common mode of transmission of germs in a
healthcare setting. Unclean hands have been the cause of innumerable infection outbreaks.
- It is assumed that the hands get contaminated only when visibly dirty areas are touched. But, apparently, clean activities like lifting patients, or checking the pulse, blood pressure or oral temperature can also contaminate hands. Even touching surfaces around the patient can contaminate the hands.
- The first evidence that hand hygiene reduces the incidence of infections was provided by Dr. Ignaz Philipp Semmelweiss, an obstetrician practicing in Vienna, Austria, in the mid-19th century.
- He observed that of two obstetric clinics, one had a significantly higher maternal mortality rate due to puerperal fever. This unit was attended to by medical students who would come directly after performing autopsies.
- Dr. Semmelweis thought that these students were probably carrying harmful germs from the autopsy to the maternity ward. To stop this, he introduced hand washing with a chlorine solution. This intervention dramatically reduced the mortality rate.
Hence, improved adherence to hand hygiene, whether by washing with soap and water or by rubbing with an alcohol-based agent, can and will reduce overall infection rates.
8. Having considered the evidence to support the importance of hand hygiene in healthcare, let us understand how organisms get onto the hands. Some of them are already resident on everyone’s hands. These are called resident flora and are present in the deeper layers of superficial skin and are a part of our normal flora. These are present in you, me and everyone, are mostly harmless, and cannot be easily removed.
The organisms that are of concern for transmission are what constitute the transient flora. These are the bugs that are acquired from the patients and the hospital environment, and remain on the skin until such time that the hands are washed.
9. The fact that infectious organisms are present on the hands is undisputed,
but how do they get transferred to the patient?
10. Transmission of infection via the hands is a 5-step process:
1. organisms will be present either on the patients or the environment surfaces.
2. So, when the HCW touches the above-mentioned areas, the organisms get transferred onto the HCW’s hands.
3. some of these organisms can survive and persist on the hands for periods ranging from a few minutes to a few hours.
4. the organisms continue to remain and thrive on the HCW’s hands because the hands have not been washed immediately post-contact.
5. these contaminated hands can easily transfer the organism to the next patient and the surrounding environment.
11. What if organisms do get transferred to susceptible patients? Does it matter?
Yes, it does. They can result in HCAIs. The patients are usually vulnerable due to the severity of their primary illness and the many devices and tubing’s that have been introduced. These infections could affect any site or system of the body and could be as serious as septicemia.
12. Before we proceed, let us get acquainted with certain terms:
Hand hygiene: This refers to the actual washing of the hands, an antiseptic hand wash, an alcohol-based hand rub, and surgical hand hygiene/antisepsis with a view to reduce the overall microbial burden of transient flora
Hand washing: When soap and water is used, the process is called hand washing.
Antiseptic hand wash: If an antiseptic agent is also used with soap, then it is considered an antiseptic hand wash.
Alcohol-based hand rub: This involves rubbing an alcohol-containing preparation onto the hands to sanitize them.
Surgical hand hygiene/antisepsis: This is an antiseptic hand wash or an alcohol-based hand rub, done by surgical personnel. The difference between a regular wash/scrub and a surgical wash/scrub is that
- the duration is longer (up to 5 minutes);
- the surface area cleaned is wider and the process takes care of both transient flora as well as some resident flora.
13. Which of these two parameters does hand hygiene refer to?
- Removal or killing of the microorganisms on the hands.
- Maintaining good skin integrity.
Hand hygiene refers to both of them, because if the skin integrity is compromised, the germs can sit in the minute cracks on the skin, multiply and play havoc.
14. What does hand hygiene achieve?
It prevents the transfers of germs from the HCW’s hands to not only the patients but also onto the HCW’s person. Thus, it protects both the HCW and the patients.
15. The two processes, hand rub and hand wash differ in their outcome.
Whereas a hand rub with an alcohol-based solution kills organisms in seconds, a hand wash with soap and water removes the microbes, provided both are done correctly.
16. For more information on hand hygiene, you can refer to the guidelines published by the WHO.
17. Without doubt, it is important to clean the hands as frequently as possible, but are there some indications as to when hand hygiene should definitely be done?
Yes. These can be remembered as the five necessary moments of hand hygiene:
- Before contact with a patient.
- Before performing an aseptic task.
- After risk of exposure to body fluids.
- After patient contact.
- After contact with a patient’s surroundings.
While moments ii, iii and iv may be practiced frequently, it is important not to miss moments i and v.
18. Some examples of moment i include shaking hands, checking the pulse or blood pressure, abdominal palpation, and even before adjusting the I.V. tube rate.
19. Some examples of the moment ii are administering eye drops, wound dressing, catheter insertion, and preparation of medications and dressing sets.
20. Some examples of moment iii are oral/dental care, drawing and manipulating fluid sets, and clearing up secretions and excretion.
21. Examples of moment iv are similar to the moment i, with a few additions like clearing the bedside table or adjusting the perfusion speed.
22. Is there a method to how hand hygiene is to be performed?
The hands washing process requires a source of running water, liquid soap and clean towels. It also requires 15 seconds each time; so, the magic number you need to remember is 15.
23. It is important to dry hands thoroughly with a clean towel after washing. Hands should be dry because wet hands are an open invitation for bacteria and the transfer through wet hands is more efficient.
24. Concentrate on these images below which depict the steps of effective hand washing. there are six areas that should never be missed and it is important to follow this sequence:

25. Otherwise, the orange-colored areas are likely to be missed.
26. The differences between the three techniques of hand hygiene — a regular hand wash, a hand rub and a surgical hand scrub — are as follows:
Hand wash |
Hand rub |
Surgical Hand Scrub |
When visibly soiled or dirty |
No visible
soil/dirt |
Done before all surgeries and other invasive procedures needing strict asepsis |
With soap and water |
with an alcohol-based hand rub |
With antiseptic soap and water |
up to the wrist |
up to the wrist |
Scrub vigorously up to the elbows
Also, clean under the nail bed |
Rub for 15 seconds |
Rub until dry |
2–5 minutes |
Dry with a clean, single-use towel/paper napkin |
No water or towel needed. |
Use a sterilized towel for drying |
27. When hands are visibly soiled, hand washing is the method of choice. In all other situations, an alcohol-based hand rub is preferred. A surgical scrub should be done before procedures that require strict asepsis.
28. There are three agents that are used for hand hygiene:
- Ordinary soap
- Antibacterial soap
- Alcohol-based hand rub
29. As far as their killing efficiency is concerned, an alcohol-based hand rub is better than antimicrobial soap, which in turn is better than plain soap.
30. Antibacterial soap should be used in high-risk areas.
31. 15 seconds is the magic time for a hand wash and even a hand rub, which should be remembered by all HCWs.
32. Alcohol-based hand rubs are preparations that contain alcohol in concentrations ranging from 60% to 90%.
- They kill more effectively.
- They kill more quickly.
- They require less time.
- Importantly, an alcohol-based hand rub should not be followed by a water rinse.
33. Effective hand hygiene calls for certain pre-requisites: Short and clean nails, no artificial nails, no rings or bracelets and other hand jewellery, no nail polish and short-sleeved garments.
34. Practicing hand hygiene has immense proven benefits in healthcare. An increase in hand hygiene adherence by only 20% resulted in a 40% reduction in the HCAI rate.
35. HCWs should always remember that gloves are not a replacement for hand hygiene.
36. Hand hygiene is the single most important means of preventing infection.
37. Hand hygiene saves lives and, potentially, can save millions of lives. The lives of patients are indirectly in your hands; keep them hygienic at all times.
|